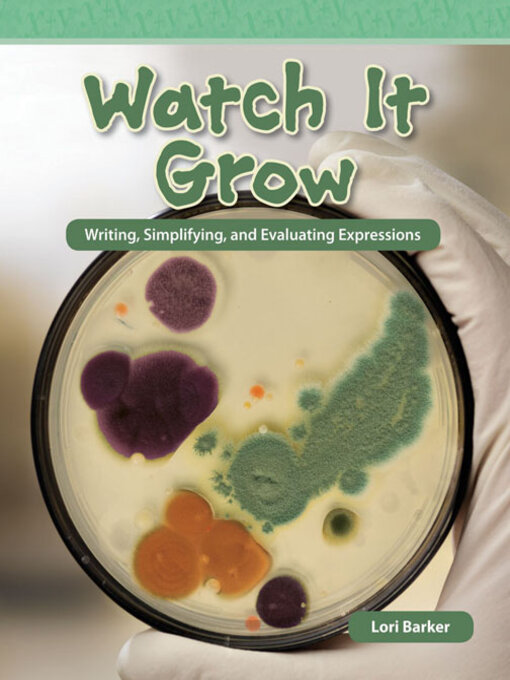
Title details for Watch It Grow by Lori Barker - Available

- Available Now
- Indigenous Voices of Canada
- Historical Fiction
- Mystery
- Thrillers
- Romance
- Classics
- Comics and Graphic Novels
- Science Fiction
- Fantasy
- Horror
- Cooking & Food
- Travel
- See all ebooks collections
- Available Now
- Indigenous Voices of Canada
- Always Available Audiobooks
- Great Narrators
- Read by the Author
- Ultimate Performance: Full Cast Audio
- Audiobooks Under 3 Hours
- Poetry is Meant to be Spoken
- Award-Winning Audiobooks
- See all audiobooks collections
- Newly Added Magazines
- Lifestyle
- Cooking & Food
- News & Politics
- Celebrity
- See all magazines collections